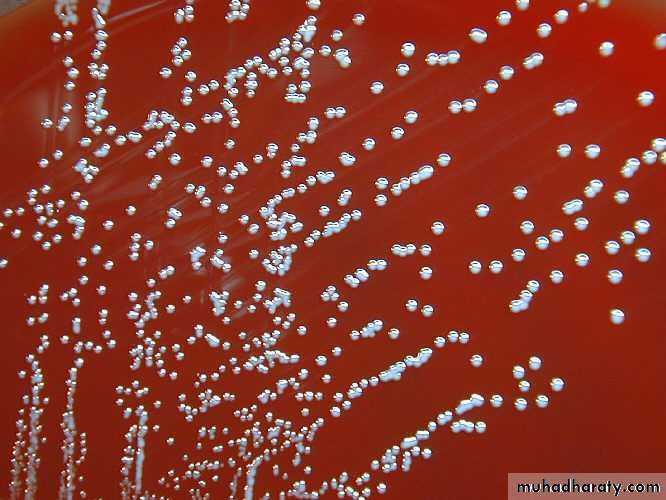

Brucellae
Model AQ2: In thayer martin media used antimicrobial agent , discuss this statements?
Q4: Colonies of Pseudomonas on macconkey appear-------- while on Nutreient can be distingueshed by?
Model B
Q1: Enumerate, virulence factors of meningococcus, and explain their roles in pathogenicity?Q3: Pseudomonas aeruginosa can be considered as a major human pathogen? Why?
The microorganism responsible for Malta fever was discovered by a British Army physician, Sir David Bruce, on July 9, 1887, which he called Micrococcus melitensis. It was isolated from the spleen of a British soldier who had died of the disease. He also identified that the organism grew best at higher temperatures and speculated that this accounted for the increased frequency of cases in hot summer months. He later established goats as the main reservoir for infection by identifying the organism in their blood, urine, and milk. This discovery helped explain the epidemiology of the disease. For example, officers were three times more likely to become ill because they drank more milk than private soldiers, and large numbers of cases were found in hospitals where milk was widely distributed.
The brucellae are obligate intra-cellular parasites of animals and humans . Brucella melitensis typically infects goats; Brucella suis, swine; Brucella abortus, cattle; and Brucella canis, dogs. The disease in humans, brucellosis (undulant fever, Malta fever), is characterized by an acute bacteremic phase followed by a chronic stage that may extend over many years and may involve many tissues.
Source of infection
The Many Names of Brucellosis
Human Disease
Malta Fever
Undulant Fever
Mediterranean Fever
Rock Fever of Gibraltar
Gastric Fever
Brucellosis is a systemic infectious disease transmitted from certain animals to humans (zoonotic disease). Brucellosis in humans is predominantly caused by four different species of Brucella bacteria: Brucella melitensis (goats, sheep, camels), Brucella suis (pigs), Brucella abortus (cows, buffalo, elk, camels, yaks), and Brucella canis(dogs). Though all of these species can cause human brucellosis, Brucella melitensis is the most prevalent worldwide, and it is felt to cause the most severe cases of brucellosis.
Morphology & Identification
The bacteria varies from cocci to rods with short coccobacillary forms predominating. They are gram-negative , aerobic, non-motile, Catalase and oxidase are positive and non-spore-forming . They produce small, convex, smooth colonies on enriched media in 2–5 days. Hydrogen sulfide is produced by many strains, and nitrates are reduced to nitrites.Differentiation among brucella species or biovars is made possible by their characteristic sensitivity to dyes and their production of H2S.
Gram negative of Brucella spp
Colonies of brucella on enriched media
Brucella (gram stain) G-ve,
Virulence factors
1-adhesins used for adhesion of brucella by epithelial cells2- LPS which include lipid A
3-lipoprotein
4- type IV secretion system (vir B and periplasmic cyclic beta, 1,2 glucans)
Pathogenesis & Pathology
The common routes of infection in humans are the intestinal tract (ingestion of infected milk), mucous membranes (droplets), and skin (contact with infected tissues of animals). The organisms progress from the portal of entry via lymphatic channels and regional lymph nodes to the thoracic duct and the bloodstream which distributes them to the parenchymatous organs. Granulomatous nodules that may develop into abscesses form in lymphatic tissue, liver, spleen, bone marrow, and other parts of the reticuloendothelial system.Clinical Findings
Disease in HumansIncubation period
Variable; 5 days to three months
Multisystemic
Any organ or organ system
Cyclical fever
Flu-like illness
Chronic illness possible
Complications of Brucellosis
Most common
Arthritis, spondylitis, epididymo-orchitis, chronic fatigue
Neurological
5% of cases
Other
Ocular, cardiovascular, additional organs and tissues
Congenital Brucellosis
Variable symptomsPremature delivery
Low birth weight
Fever
Failure to thrive
Jaundice
Hepatomegaly
Splenomegaly
The incubation period is 1–6 weeks. Early symptoms are malaise, fever, weakness, aches, and sweats. The fever usually rises in the afternoon. There may be gastrointestinal and nervous symptoms. Lymph nodes enlarge, and the spleen becomes palpable. Hepatitis may be accompanied by jaundice. Deep pain and disturbances of motion, particularly in vertebral bodies, suggest osteomyelitis.
Following the initial infection, a chronic stage may develop, characterized by weakness, aches and pains, low-grade fever, nervousness, and other nonspecific manifestations compatible with psychoneurotic symptoms.
Diagnostic Laboratory Tests
Specimens
Blood should be taken for culture, biopsy material for culture (lymph nodes, bone, etc), and serum for serologic tests.
Culture
Brucella agar , trypticase soy medium with or without 5% sheep blood, brain heart infusion medium, and chocolate agar. Blood culture media readily grow brucella species . All cultures incubate in 8–10% CO2 at 35–37 °C and observed for 3 weeks before being discarded as negative .After a few days of incubation on agar media, the brucellae form colonies in the primary streak that are < 1 mm in diameter , nonhemolytic. The observation of tiny gram-negative coccobacilli that are H2S-production , catalase-positive and oxidase-positive suggests brucella species. A positive urease test is characteristic of brucella species.
Serology
ELISA: it measures IgM,IgG and IgA allowing for better interpretation.Polymerase chain reaction (pcr): PCR
it is used for rapid and accurate diagnosis of brucellosis.• Treatment
• The cornerstone of treatment for brucellosis is antibiotics. Because of the high relapse rate associated with the disease, the use of a multidrug (two or more) antibiotic regimen is recommended. The antimicrobials most commonly used include doxycycline (Vibramycin), streptomycin, rifampin (Rifadin), gentamicin (Garamycin), and trimethoprim-sulfamethoxazole(Bactrim, Septra). The combination of antibiotics used will vary based on disease severity, age and pregnancy.Treatment
In general, a full six-week course of antibiotics is recommended, and prompt treatment can lead to an improvement in symptoms and may also prevent the complications associated with brucellosis. However, relapse rates of the disease are still about 5%-10%, even with treatment. Depending on the severity of illness, the associated complications (if any) and the timing of treatment, recovery may take from a few weeks to a few months.Brucell treatmen:
Doxycycline+rifampin
Trimethoprim-sulfamethoxazole for pregnant women and for children younger than 8 years
6 weeks or longer
Fluoroquinolones, macrolides, penicillins, and cephalosporins either ineffective or have unpredictable activity.
Epidemiology, Prevention, & Control
Brucellae are animal pathogens transmitted to humans by accidental contact with infected animal feces, urine, milk, and tissues. The common sources of infection for humans are unpasteurized milk, milk products and cheese and occupational contact (eg, farmers, veterinarians, slaughterhouse workers) with infected animals. Because of occupational contact, brucellae infection is much more frequent in men.Control rests on limitation of spread and possible eradication of animal infection, pasteurization of milk and milk products, and reduction of occupational hazards wherever possible.